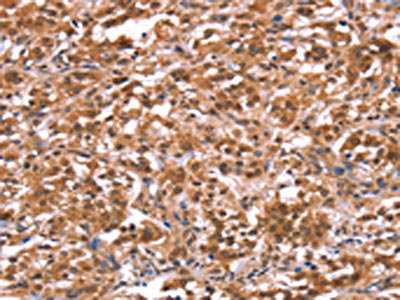

AMER1 Antibody
-
中文名稱:AMER1兔多克隆抗體
-
貨號:CSB-PA281738
-
規格:¥1100
-
圖片:
-
The image on the left is immunohistochemistry of paraffin-embedded Human thyroid cancer tissue using CSB-PA281738(AMER1 Antibody) at dilution 1/40, on the right is treated with synthetic peptide. (Original magnification: ×200)
-
The image on the left is immunohistochemistry of paraffin-embedded Human gastric cancer tissue using CSB-PA281738(AMER1 Antibody) at dilution 1/40, on the right is treated with synthetic peptide. (Original magnification: ×200)
-
-
其他:
產品詳情
-
Uniprot No.:
-
基因名:
-
別名:AMER1 antibody; FAM123B antibody; WTXAPC membrane recruitment protein 1 antibody; Amer1 antibody; Protein FAM123B antibody; Wilms tumor gene on the X chromosome protein antibody
-
宿主:Rabbit
-
反應種屬:Human,Mouse
-
免疫原:Synthetic peptide of Human AMER1
-
免疫原種屬:Homo sapiens (Human)
-
標記方式:Non-conjugated
-
抗體亞型:IgG
-
純化方式:Antigen affinity purification
-
濃度:It differs from different batches. Please contact us to confirm it.
-
保存緩沖液:-20°C, pH7.4 PBS, 0.05% NaN3, 40% Glycerol
-
產品提供形式:Liquid
-
應用范圍:ELISA,IHC
-
推薦稀釋比:
Application Recommended Dilution ELISA 1:2000-1:5000 IHC 1:50-1:200 -
Protocols:
-
儲存條件:Upon receipt, store at -20°C or -80°C. Avoid repeated freeze.
-
貨期:Basically, we can dispatch the products out in 1-3 working days after receiving your orders. Delivery time maybe differs from different purchasing way or location, please kindly consult your local distributors for specific delivery time.
-
用途:For Research Use Only. Not for use in diagnostic or therapeutic procedures.
相關產品
靶點詳情
-
功能:Regulator of the canonical Wnt signaling pathway. Acts by specifically binding phosphatidylinositol 4,5-bisphosphate (PtdIns(4,5)P2), translocating to the cell membrane and interacting with key regulators of the canonical Wnt signaling pathway, such as components of the beta-catenin destruction complex. Acts both as a positive and negative regulator of the Wnt signaling pathway, depending on the context: acts as a positive regulator by promoting LRP6 phosphorylation. Also acts as a negative regulator by acting as a scaffold protein for the beta-catenin destruction complex and promoting stabilization of Axin at the cell membrane. Promotes CTNNB1 ubiquitination and degradation. Involved in kidney development.
-
基因功能參考文獻:
- A novel heterozygous frameshift mutation in AMER1 was identified in a patient with osteopathia striata with cranial sclerosis. PMID: 28893644
- Losses of AMER1 by other mechanisms apart from mutations. PMID: 26071483
- A nonsense mutation (c.1045C>T, p.Glu349*) in the WTX gene. PMID: 24459086
- WTX inactivation occurs in a wider variety of tumor types than previously appreciated and point to shared pathogenic mechanisms between a subset of pediatric malignancies. PMID: 24249259
- Data indicate that osteopathia striata congenita with cranial sclerosis (OSCS) iscaused by germline deletions of in the X-linked gene WTX (FAM123B, AMER1). PMID: 22670894
- Two novel WTX mutations underscore the unpredictability of male survival in osteopathia striata with cranial sclerosis. PMID: 20950377
- Stat3 inhibits WTX expression through up-regulation of micro RNA-370 in Wilms tumor. PMID: 23333300
- Osteopathia striata with cranial sclerosis or Horan-Beighton syndrome is a rare X-linked dominant inherited bone dysplasia. Genetic analysis allowed the identification of maternally transmitted heterozygous nonsense c.1057C>T (p.R353X) WTX mutation. PMID: 22716240
- WTX mutations occur early in Wilms' tumor development, but at a low proportion. There was no evidence that WTX is the main cause of Wilms' tumor. PMID: 22800892
- WTX modulates p53 function, in part through regulation of its activator CBP/p300. PMID: 22285752
- WTX and NRF2 compete for binding to KEAP1, and thus loss of WTX leads to rapid ubiquitination and degradation of NRF2 and a reduced response to cytotoxic insult. PMID: 22215675
- Amer1 exerts its negative regulatory role in Wnt signaling by acting as a scaffold protein for the beta-catenin destruction complex and promoting stabilization of Axin at the plasma membrane. PMID: 21498506
- WTX mutations can arise both early and late in Wilms tumour development PMID: 20679664
- When gene expression changes mediated by wild-type WTX were compared with those affected by mutant WTX, WTX565 had a 55% overlap in differentially regulated genes, whereas WTX358 regulated only two genes affected by wild-type WTX. PMID: 20956941
- Mutations in the WTX-gene are associated with high-grade microsatellite instable colorectal cancers. PMID: 20696052
- inactivation of WTX appears to be a late event in tumorigenesis of nephroblastoma in a subgroup of nephroblastomas PMID: 19757195
- All investigated families diagnosed with Osteopathia striata with cranial sclerosis had WTX gene defects. PMID: 20209645
- WTX, is inactivated in approximately one-third of Wilms tumors; it is inactivated by a monoallelic "single-hit" event targeting the single X chromosome in tumors from males and the active X chromosome in tumors from females PMID: 17204608
- findings show that WTX, a protein encoded by a gene mutated in Wilms tumors, forms a complex with beta-catenin, AXIN1, beta-TrCP2 and APC; data provide a possible mechanistic explanation for the tumor suppressor activity of WTX PMID: 17510365
- Deletion of the WTX gene is associated with Wilms' tumor with a balanced translocation t(X;18) PMID: 17620295
- These data indicate that AMER1 controls the subcellular distribution of APC between membrane- and microtubule-associated pools, and might thereby regulate APC-dependent cellular morphogenesis, cell migration and cell-cell adhesion. PMID: 17925383
- Gene has a tumor suppressor function in Wilms tumors, and is involved in beta-catenin destruction. PMID: 18021721
- WT1 and WTX mutations occur with similar frequency, that they partially overlap in Wilms tumors, and that mutations in WT1, WTX, and CTNNB1 underlie the genetic basis of about one-third of Wilms tumors PMID: 18311776
- Functional inactivation of the WTX gene is not a frequent event in Wilms' tumors. PMID: 18391980
- there was not any evidence of WTX mutation in the 143 acute leukemia patients PMID: 18452086
- WTX is rarely mutated in acute myeloid leukemia PMID: 18460646
- Data indicate that WTX mutation is rare in colorectal, gastric, and hepatocellular carcinomas. PMID: 18720004
- The observed phenotypic discordance dependent upon whether a mutation is germline or occurs somatically suggests the existence of temporal or spatial constraints on the action of WTX during tumorigenesis. PMID: 19079258
- Mutations in WTX gene is associated with Wilms tumor. PMID: 19137020
- WTX binds WT1 and enhances WT1-mediated transcription, suggesting a role for WTX in nuclear pathways implicated in the transcriptional regulation of cellular differentiation programs PMID: 19416806
- WTX inactivation is associated with Wilms tumors PMID: 19760609
顯示更多
收起更多
-
相關疾病:Osteopathia striata with cranial sclerosis (OSCS)
-
亞細胞定位:Cytoplasm. Cell membrane; Peripheral membrane protein; Cytoplasmic side. Nucleus. Note=Shuttles between nucleus and cytoplasm. Detected in nuclear paraspeckles that are found close to splicing speckles. Translocates to the cell membrane following binding to PtdIns(4,5)P2.
-
蛋白家族:Amer family
-
組織特異性:Detected in fetal and adult kidney, brain and spleen.
-
數據庫鏈接:
Most popular with customers
-
-
YWHAB Recombinant Monoclonal Antibody
Applications: ELISA, WB, IHC, IF, FC
Species Reactivity: Human, Mouse, Rat
-
Phospho-YAP1 (S127) Recombinant Monoclonal Antibody
Applications: ELISA, WB, IHC
Species Reactivity: Human
-
-
-
-
-